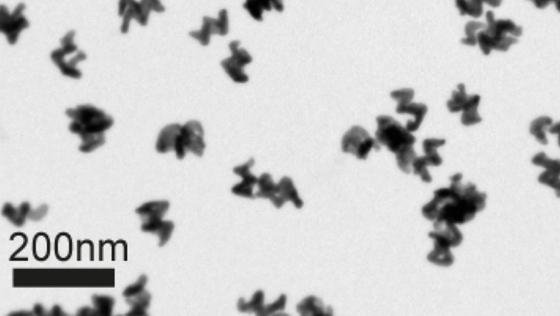

Nano-Bauteile nun in jeder Form
Kühne Vorstellungen, was sich mit Nano-Bauteilen wohl eines Tages machen lassen werde, gibt es seit langer Zeit. Diese Ideen krankten bislang aber wesentlich daran, dass sich derartige Bauteile nur in ganz wenigen Formen erzeugen ließen. Bauteile mit weniger als 100 Nanometern Größe ließen sich im Wesentlichen nur völlig symmetrisch und kugelartig produzieren. Genau das ändert sich nun.
Nanospiralen als Lichtantennen: Die winzigen Nanostrukturen lassen sich mit einer neuen Methode sehr präzise und in großer Zahl herstellen. Durch die Abmessungen und die Zusammensetzung der Helices lässt sich steuern, welche Lichtfarbe sie absorbieren. Sie eignen sich um zirkular polarisiertes Licht zu filtern.
Foto: Andrew G. Mark
Ein Forscherteam unter Leitung von Professor Peer Fischer vom Max-Planck-Institut für Intelligente Systeme in Stuttgart hat eine Methode entwickelt, die es jetzt erlaubt, Materialien mit gänzlich unterschiedlichen chemischen wie auch physikalischen Eigenschaften zu besonders vielfältigen Nanostrukturen zu kombinieren. Damit sind ausdrücklich zugleich auch ungewöhnliche Formen möglich geworden, die den Einsatz von Nano-Bauteilen für ganz neue Verwendungszecke erlauben.
Parallel mehrere Milliarden Nano-Bauteile herstellen
Technische Basis dieses Verfahrens ist eine tiefgekühlte, drehbare Scheibe. Auf dieser Scheibe züchten die Stuttgarter Forscher aus dem Dampf der ausgewählten Komponenten die gewünschten Nano – Strukturen. Diese Methode erlaubt es nicht nur, diese Strukturen viel exakter als mit jedem anderen Verfahren vorzugeben sondern ermöglicht zugleich auch, binnen kürzester Zeit parallel bis zu mehreren Milliarden Nano-Bauteile herzustellen.
Konkret haben die Stuttgarter Forscher unter anderem nanoskopische Stäbchen, Haken, Schrauben sowie Zick-Zack – Strukturen produziert. Für die Herstellung dieser Nano-Bauteile wurden die verschiedensten Materialien mit gänzlich unterschiedlichen Eigenschaften verwandt. Dazu zählten beispielsweise Metalle, Halbleiter, magnetische Stoffe und Isolatoren. Was inzwischen schon möglich ist, zeigt das Beispiel der Gold-Helices, also Goldpartikelchen, die sich als Nano-Antennen für Licht eignen.

Nanostrukturen aus der Parallelproduktion: Mehrere 100 Milliarden Helices, aber auch Haken oder Zickzack-Strukturen lassen sich mithilfe der Dampfabscheidung auf einem vorstrukturierten Wafer erzeugen (a). Ultraschall entfernt die Nanobauteile von dem Träger, sodass sie in eine Lösung gebracht werden können (b). Form und Abmessungen der Strukturen lassen sich sehr exakt kontrollieren (c,d).
Quelle: Andrew G. Mark
Die Drehung der Gold-Helix bestimmt dabei zugleich auch die Drehrichtung der Nano-Antenne. Welche Lichtfarbe diese Antenne dabei absorbiert, lässt sich über deren Form und Zusammensetzung genau bestimmen. Mittels dieser Antennen lässt sich polarisiertes Licht, wie es etwa bei der Projektion von 3D-Filmen verwendet wird, filtern. In einem solchen Licht dreht sich die Schwingungsebene der elektromagnetischen (Licht-)Wellen entweder im Uhrzeiger-Sinn oder in Gegenrichtung.
Genaue Kontrolle über Form und Zusammensetzung der Bauteile
Die unumgängliche genaue Kontrolle über die Formen und die Zusammensetzung der Nano-Bauteile wird durch die Nutzung der schon vor mehreren Jahren entwickelten mizellaren Nano-Lithographie möglich. Als erster Schritt werden dabei Milliarden regelmäßig angeordneter Gold-Nanopartikelchen auf der Oberfläche eines Silizium- oder Glas-Wafers aufgetragen. Sie scheiden auf dem Träger Goldteilchen, die in eine Polymermembrane eingehüllt sind. Diese Goldteilchen reihen sich dicht aneinander und bilden dabei regelmäßige Muster. Als zweiter Schritt wird die Polymerhülle mittels eines Plasmas zerstört. Zurück bleiben die Goldpunkte. In einem dritten Schritt wird der vorstrukturierte Wafer schräg in den Strom eines Metalldampfes gerückt, so dass die Metallatome nur die Goldinseln sehen und sich auf ihnen absetzen. Dabei wachsen auf dem Träger rasch Stäbchen, die bis zu 20 Nanometern dünn sein können.
Wird dieser Träger während des Aufdampfens langsam gedreht, so windet sich das einzelne Stäbchen zu einer Helix. Wird der Träger dagegen abrupt gekippt, so bildet sich eine Zick-Zack-Form. Wird zwischendurch das aufzudampfende Material verändert, so entsteht ein Verbundmaterial. Was so alles möglich ist, zeigt das Beispiel der Stäbchen aus Aluminium-Oxid mit Kupferhaken. Dabei wurde eine dünne Titan-Schicht als Kleber genutzt. Voraussetzung all dieser Produktionsvorgänge ist eine Kühlung mit flüssigem Stickstoff, der bei minus 200 Grad Celsius zu einer Art Schock-Gefrostung der Metallatome führt.
Grenzen des Verfahrens
Zwangsläufig hat auch das Verfahren der Stuttgarter Forscher gewisse Grenzen. Gerade weil die Strukturen stets vom Träger wegwachsen, lassen sich damit keine Ringe oder geschlossene Drei- und Vierecke produzieren. Erklärtes Ziel von Professor Fischer ist es, Nanomaschinen zu bauen, wobei vielfältige Einrichtungen in der Natur als Muster dienen. Fischer: “ „Die Natur baut Motoren in einer Größe von etwa 20 Nanometern. Wir möchten unsere Bauteile an solche Motoren koppeln.“
Ein Beitrag von:
















